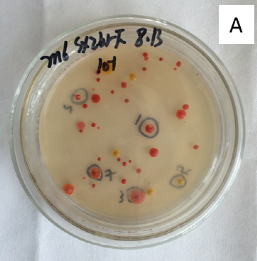
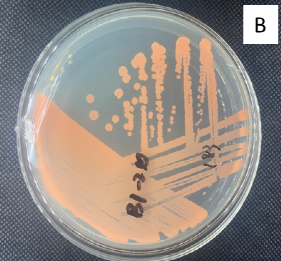

为进一步提高《微生物组实验手册》稿件质量,本项目新增大众评审环节。文章在通过同行评审后,采用公众号推送方式分享全文,任何人均可在线提交修改意见。公众号格式显示略有问题,建议电脑端点击文末阅读原文下载PDF审稿。在线文档(https://kdocs.cn/l/cL8RRqHIL)大众评审页面登记姓名、单位和行号索引的修改建议。修改意见的征集截止时间为推文发布后的72小时,文章将会结合有建设性的修改意见进一步修改后获得DOI在线发表,同时根据贡献程度列为审稿人或致谢。感谢广大同行提出宝贵意见。
为进一步提高《微生物组实验手册》稿件质量,本项目新增大众评审环节。文章在通过同行评审后,采用公众号推送方式分享全文,任何人均可在线提交修改意见。公众号格式显示略有问题,建议电脑端点击文末阅读原文下载PDF审稿。在线文档(https://kdocs.cn/l/cL8RRqHIL)大众评审页面登记姓名、单位和行号索引的修改建议。修改意见的征集截止时间为推文发布后的72小时,文章将会结合有建设性的修改意见进一步修改后获得DOI在线发表,同时根据贡献程度列为审稿人或致谢。感谢广大同行提出宝贵意见。
盐湖微生物的分离培养及保藏方法
Isolation and preservation of microorganisms in salty lake
刘永红1,刘冰冰3,李文均1,2,*
1荒漠与绿洲生态国家重点实验室,中国科学院新疆生态与地理研究所,乌鲁木齐,新疆;2 生命科学学院,中山大学,广州,广东;3河南省工业微生物资源与发酵技术重点实验室,南阳理工学院,南阳市,河南
*通讯作者邮箱: liwenjun3@mail.sysu.edu.cn
方法一: 嗜盐细菌分离保藏方法
摘要:盐湖环境具有高渗透压或高pH等特点,生长条件苛刻,但却蕴藏着丰富、独特、宝贵的嗜盐微生物资源,如嗜盐细菌,嗜盐放线菌和嗜盐古菌等。生长在高盐环境中的微生物往往需要一定的盐浓度,从而保持正常生理所需的渗透势。因此,在分离嗜盐菌时,需在分离培养基中添加合适的盐,以期获得具有不同渗透特性的微生物类群,从而提高分离菌株的多样性。实验者也可根据自身样品的理化性质对分离培养基和培养条件进行优化和调整,以达到更好的分离效果,充分发掘盐湖环境微生物资源。本部分阐述的方法适用于分离盐湖中可培养嗜盐细菌。在实验室条件下分离培养盐湖环境中的嗜盐细菌,初步了解盐湖可培养嗜(耐)盐细菌类群。本实验所获菌株根据需要,分别采用以甘油为保护剂和以牛奶为保护剂的方法进行高效保藏,为后续新分类单元的鉴定、功能菌株的筛选以及代谢产物的发掘提供优质的微生物资源。
关键词: 盐湖,分离,纯培养,细菌,保藏
材料与试剂
1.无机盐:NaCl,KCl,CaCl2,KNO3,CaCO3,FeSO4·7H2O,KH2PO4,K2HPO4,MnCl2·4H2O,MgCl.6H2O,ZnSO4·7H2O, MgSO4·7H2O,丙酸钠,柠檬酸三钠等;
2.碳源或氮源:可溶性淀粉,葡萄糖,甘油,酵母粉,蛋白胨,干酪素,纤维素等;
3.成品培养基:Marine Broth 2216(BD, Difco),R2A(青岛海博)等;
4.其它溶剂和试剂:琼脂,酪蛋白水解物,脱脂奶粉,甘油,制霉菌素,Chelex,等;
5.实验用品和耗材:研钵,研磨棒,涂布棒,接种针,90 mm的无菌培养皿, 15 mL无菌离心管,100 mL的锥形瓶,各种型号的移液器吸头 (20 μL, 200 μL, 1000 μL),天平,记号笔,酒精灯,酒精喷灯,安瓿瓶,2 mL的冻存管,电磁炉等。
仪器设备
仪器名称 | 型号 | 生产厂家 |
立式压力蒸汽灭菌器 | LDZH-100KBS | 上海申安医疗器械厂 |
电热恒温培养箱 | GHP-9160 | 上海天呈实验仪器制造有限公司 |
烘箱 | XMTD-8222 | 上海精宏实验设备有限公司 |
迷你离心机 | LX-200 | 江苏海门市其林贝尔仪器制造有限公司 |
小型振荡器 | MS 3 basic | 德国IKA |
PCR仪 | C1000 | 美国Bio-RAD |
洁净工作台 | SW-CJ-2FD | 上海博迅医疗生物仪器股份有限公司 |
电子精密天平 | BSA 124S | 德国Sartorius |
电子分析天平 | TE 1502S | 德国Sartorius |
冰箱 | BCD-308W | 青岛海尔股份有限公司 |
超低温冰箱 | UXF70086V | Thermo SCIENTIFIC |
摇床 | TS-211B | 上海天呈实验仪器制造有限公司 |
软件和数据库
MEGA 7.0(https://www.megasoftware.net/)
EzBioCloud (https://www.ezbiocloud.net/)
1.实验步骤试验前准备
1.1提前准备好实验样品,根据样品数量和性质选择所要配置的培养基种类和用量;
1.2计算所需物品的数量:研钵,100 mL锥形瓶,90 mm培养皿,涂布棒,15 mL离心管,10 mL注射器,0.22 μm无菌有机系滤膜,不同规格的移液器吸头 (20 μL, 200 μL, 1,000 μL) 等,提前找好备用;
1.3准备好适量的玻璃珠和蒸馏水等备用。
2.分离培养基的配置
首先根据样品数量和试验重复计算所需培养基的用量,然后根据配方称取和配制适量的培养基,调至合适pH,高温灭菌后,待培养基冷却至50 °C左右,以1 mL/L的浓度加入制霉菌素原液,使之与无菌培养基充分混匀,自然风干2-3 d备用。
注:每种培养基在配置过程中,可根据样品本身的特性和实验需要,设置不同盐梯度,如5 %、10 %、15 %、20 %和25 %等,以此添加不同质量的NaCl或者KCl, NaCl和MgCl2等复合盐。涂板时每个处理做2个重复。
培养基配方参考如下 (g/L) :
2.11/2 MA培养基:取Marine Agar 2216培养基成品18.7 g,琼脂18 g, pH 7.2,于121 °C高压灭菌30 min。
2.21/2 R2A培养基:酵母粉,蛋白胨,酪蛋白水解物,葡萄糖,可溶性淀粉各0.25 g;K2HPO4和丙酮酸钠分别0.15 g; MgSO4 0.001 g,琼脂20 g, pH 7.2,于121 °C高压灭菌30 min。
2.3MGM培养基:人工合成盐水,蛋白胨5 g,酵母粉1 g,琼脂20 g。人工盐水组成:NaCl 190 g; MgCl.6H2O 25 g; MgSO4.7H2O 30 g; KCl 15 g。盐水单独灭菌,基础培养基用1M Tris-HCl调制pH 7.5,于121 °C高压灭菌30 min,待温度冷却至50-60 °C时将人工盐水和基础培养基混合再倒板 (赵婉雨,2013) 。
2.4CCMS培养基:纤维素10 g,干酪素0.3 g, KNO3 0.2 g, MgSO4·7H2O 0.05 g, CaCO3 0.02 g, FeSO4 0.01 g, KCl 20 g, MgCl2 30 g, NaCl 50/100/150 g,琼脂糖15 g, pH 7.5 (田蕾等,2017) 。
2.5CM培养基:酪蛋白水解物 7.5 g, 酵母粉 10 g, 柠檬酸三钠 3 g, KCl 2 g, MgSO4·7H2O 20 g , FeSO4·7H2O 0.05 g, NaCl 200 g, pH 7.2 (顾晓颖等,2007) 。
2.6改良高氏一号培养基:可溶性淀粉 (Soluble starch) 20 g; KNO3 1 g; MgSO4·7H2O 0.5 g (原培养基为0.05 g); K2HPO4 0.5 g(原培养基为0.05 g); Agar 12 g;微量盐1 mL (夏占峰等,2011) 。
3.样品预处理及稀释
3.1水样的预处理
对于水体中的嗜盐细菌,一般采用直接稀释涂布的方法。但为提高实验的可行性,可对水样中的菌体先通过滤膜处理进行富集。
1)直接稀释培养
a.将水样按照1:100的比例加入液体培养基中
b.120 r/min, 37 °C恒温振荡培养2-3d (此时水体的稀释倍数为10-2)
c.继续将其稀释至10-3和10-4备用
2)滤膜富集
a.在无菌条件下,将水样混匀
b.用装有0.22 µm孔径滤膜的滤器过滤,在滤膜上富集菌体,用于富集的水样量达到30 mL时,取下滤膜
c.将上一步骤所得滤膜放入装有3 mL的无菌5% NaCl溶液的玻璃试管中 (此时水样的稀释倍数为10-1)
d.继续用无菌的5% NaCl溶液将其稀释至10-3和10-4备用 (沈硕,2017) 。
3.2底泥样品的预处理
对于底泥样品,通常采用直接分离的方法培养细菌,但也可根据不同的实验目的先进行选择性富集再分离培养。
1)直接分离培养
a.在无菌条件下称取5 g底泥样品,加入45 mL无菌的5% NaCl溶液的三角瓶内 (事先已装入玻璃珠并灭好菌)
b.于摇床中120 r/min充分振荡培养30 min
c.静置,吸取上清液 (此上清液稀释倍数为10-1)
d.继续用无菌的5% NaCl溶液将其稀释至10-3和10-4备用
2)富集分离培养
a.称取40 g新鲜的底泥样品,加入装有500 mL已灭菌的富集培养基的富集瓶内
b.继续添加灭菌的富集培养液至瓶满,拧紧瓶盖达到密封效果,反复颠倒混匀
c.于25 °C恒温富集培养,每天早晚各颠倒振荡一次
d.根据富集情况的不同,分别选择富集到7天,15天或30天时的样品进行稀释涂布培养。
4.平板涂布培养
分别取每个样品稀释至10-3和10-4浓度下的悬浊液100 µL,涂布于各个分离培养基 (详见2.分离培养基的配置) ;在涂布时用涂布棒将悬浊液充分涂匀,然后在每个培养皿上做好标签,一般需要包含培养基简称、样点名、稀释梯度及时间等信息,封口后放入培养箱28 °C培养1-2周,观察并记录生长情况。
5.菌株分离纯化
待分离培养皿上的单菌落长到合适的丰度时,可开始下一步的纯化。依据菌落形态 (形状、大小、颜色及表面特征)挑取单菌落。先用记号笔在培养皿的底部标记好待纯化的菌株,并将其按顺序编号。尽量全面挑取不同形态、颜色、大小的菌落以避免重复。挑选完成后,在超净工作台中利用接种针挑取单菌落到纯化板上,采用三区划线法进行纯化。菌株纯化过程中,需要对每株菌做好标记并进行不同编号处理。当菌株在培养基中获得形态一致的单一菌落时即获得微生物的纯培养物(菌株分离及纯化效果如图1所示)。

图1. 菌株分离平板及纯化平板结果展示(A:分离板,B:纯化板)
6.菌株16S rRNA基因鉴定
挑取的单菌落在纯化培养基培养2-3 d后,基本会形成较为明显的菌落,此时可根据菌株的生长状况进行分批测序鉴定。
6.1挑取适量菌体到装有50 μL Chelex溶液的PCR管中,溶液变浑浊即可
6.2放入PCR仪器中,99 °C加热30 min
6.3离心使细胞碎片及Chelex沉降到PCR管底部,同时上清液基本澄清,此时细菌遗传物质溶解在上清液中
6.4加入1 μL上清液至配制好的PCR体系中,特异性扩增细菌DNA中的16S rRNA基因,PCR扩增程序如表1所示
6.5扩增完成后将PCR产物送至生物公司测序
表1:细菌16S rRNA基因的PCR扩增程序
温度 | 时长 | 目的 |
94℃ | 4min | 预变性 |
94℃ | 1min | 变性 |
56℃ | 30s | 退火 |
72℃ | 1min30s | 延伸 |
循环32次 | ||
72℃ | 10min | 延伸 |
4℃ | ∞ | 保存 |
7.菌株系统发育学分析
7.1所得测序结果中,选取格式为ab1的文件并用MEGA 7.0软件打开。读取相应的碱基序列,并根据测序峰的结果判断测序的可靠性,每个碱基位对应单一且明显的特征峰即为测序结果可靠(详见图2)。

图2. 采用MEGA7.0软件读取相应的测序结果
7.2确定测序结果可靠之后,将其保存为FASTA格式的文件并粘贴到EzBioCloud数据库进行比对,可得到最相似菌株。
7.3根据该属的特性及不同的实验需求,选择相似性最高的前30或者前50条序列,采用FASTA方式一次性将所需序列导出备用 (具体操作步骤详见图3) 。
1)打开网站https://www.ezbiocloud.net/,选择“16S-based ID”,打开页面后点击“Identify new sequence”
2)在相应的位置输入序列信息,然后点击“Next”进行比对
3)所得比对结果可以查看菌株的分类地位,最相似菌株,序列完整性等信息。

图3. EzBioCloud数据库16S rRNA基因相似性比对方法
7.4再次打开MEGA,点击“File”选项并选择“Open a File”,打开上一步在EzBioCloud下载的FASTA文件进行系统发育树的构建
1)打开序列时选择“Align”,打开后点击“W”图标,进一步选择“Align DNA”进行序列比对 (详细操作步骤见图4);
2)直接点击“OK”进入下一步,比对完成后删除序列前端长度不一致的序列,保留带有“*”部分的序列,依次点击“Data”和“Save as”或者直接点击键盘“Ctrl+S”键,将其保存为masx格式的文件(详细操作步骤见图5);

图4. 用MEGA软件进行多重比对的方法

图5. 用MEGA软件比对多重序列并选取有效长度
3)回到MEGA主页,点击“Phlogeny”并选择“N-J”树进行系统发育树的构建,在对话框中打开上一步保存的MASX格式文件,设定并保存相应参数,注意Bootstrap重复次数为1000次,点击“Compute”运行软件(详细操作步骤见图6);

图6. 构建N-J系统发育树
4)软件运行完成后直接生成系统发育树,此时可将系统树“Copy to Clipboard”并粘贴到PPT中进行编辑,也可点击“File”直接保存为PDF格式文件(详细操作步骤见图7)。

图7. 系统发育树的读取和保存
8.菌株保藏
实验所获得的菌株,需要对其形态特征,培养特征,分离条件,基因序列,系统分类学地位等进行详细归纳和统计,最终将具有完整信息的菌株保藏在20 %甘油管 (含5 %的NaCl) 或20 %的牛奶管 (含5 %的NaCl) ,置于-80 °C对进行长期保藏。
8.1甘油管制作流程及菌株保藏方法
1)提前准备好生长至对数期的活菌平板,确保菌株的16S rRNA基因序列验证正确无误,确保菌株无霉菌或杂菌污染,有单菌落为宜;
2)提前准备好冻存管,甘油,超纯水,接种针等备用;
3)量取100 mL超纯水,加入20 mL甘油并充分溶解,再加入5 g NaCl后再次溶解;
4)将备好的甘油NaCl溶液分装于冻存管中,每管加入1-1.5 mL即可,121 °C灭菌30 min,备用;
5)用接种针挑取适量菌体于甘油管中,混匀,甘油管外壁贴好标签备注菌株信息;
6)接种完成的甘油管置于-20 °C或-80 °C进行保存。
8.2以牛奶为保护剂的冷干管制作流程及菌株保藏方法
1)提前准备好生长至对数期的活菌平板,确保菌株的16S rRNA基因序列验证正确无误,确保菌株无霉菌或杂菌污染,有单菌落为宜;
2)提前准备好安瓿瓶,脱脂棉,牙签,脱脂牛奶,超纯水,接种针等备用;
3)将100 mL超纯水加热至40 °C左右,加入40 g脱脂奶粉,搅拌均匀,使之充分溶解,确保无块状物存在。将制备好的牛奶溶液分装于安瓿管中,每管装0.5 mL,用棉塞封好待灭菌;
4)量取100 mL超纯水,加入10 g NaCl并充分溶解,待灭菌;
5)备好的NaCl溶液于121 °C灭菌30 min备用,脱脂牛奶于115 °C灭菌10 min,灭菌完后迅速拿出,防止脱脂牛奶变黄;
6)将灭好菌的NaCl溶液在超净工作台中与牛奶管中的牛奶按照1:1混合,即每管加入0.5 mL的NaCl溶液,最终制备成20 %的牛奶管 (NaCl的含量为5 %) ;
7)用接种针从平板上挑取适量菌体于牛奶管中,混匀,牛奶管外壁贴好标签备注菌株信息;
8)接种好菌体的牛奶管尽快进行冻干处理,若不能及时冻干,确保其保藏在-80 °C;
9)冷冻干燥约24 h,取出,用酒精喷灯熔封,至此完成菌株牛奶管保藏的全过程。
结果与分析
1)比较每种培养基或不同处理之间菌株的分离频率和多样性等;
2)统计不同培养基和不同实验处理下,潜在新分类单元 的种类和数量;
3)记录和比较不同环境来源的样品中功能菌株和稀有类群的分布情况;
4)对所得结果进行excel表格信息汇总,必要时绘制堆积柱形图或饼图等;
5)同一样品的分离结果可与其相应的免培养分析结果进行比较。
注意事项
后续实验参考
1)特定功能菌株筛选,如纤维素降解功能,产酶活性,溶磷,硝酸盐还原等;
2)新分类单元的多相分类实验,当菌株与现有物种的相似性小于98.55 %时,可进一步开展分类学实验;
3)特定类群的代谢产物分析,如放线菌产抗生素研究,产胞外多糖和产PHAs(聚羟基脂肪酸类)等。
方法二: 嗜盐放线菌分离保藏方法
摘要:嗜盐放线菌作为极端生命形式的一部分,具有独特的生理特性且代谢产物多样,在抗生素、酶制剂、生物技术等方面具有巨大的潜能。在实验室条件下分离培养盐湖环境中的嗜盐放线菌,深度了解盐湖放线菌的多样性,充分挖掘盐湖环境有用放线菌资源,评估其开发应用潜力, 为今后的工业化利用奠定基础。
关键词: 盐湖,分离,纯培养,放线菌,保藏
材料与试剂
1. 无机盐:NaCl,KCl,CaCl2,KNO3,CaCO3,FeSO4·7H2O,KH2PO4,K2HPO4,MnCl2·4H2O,MgCl.6H2O,ZnSO4·7H2O,MgSO4·7H2O,丙酮酸钠,柠檬酸三钠等;
2. 碳源或氮源:可溶性淀粉,葡萄糖,甘油,精氨酸,酵母粉,蛋白胨,胰蛋白胨,干酪素,纤维素,酸水解酪蛋白,藕粉,麦芽膏等;
3. 其它溶剂和试剂:琼脂,脱脂奶粉,甘油,水解酪素,制霉菌素,Chelex等;
4. 实验用品和耗材:研钵,研磨棒,涂布棒,接种针,90 mm的无菌培养皿, 15 mL无菌离心管,100 mL锥形瓶,各种型号的移液器吸头 (20 μL, 200 μL, 1000 μL),天平,记号笔,酒精灯,酒精喷灯,安瓿瓶,2 mL冻存管,电磁炉等。
仪器设备
同方法一
软件和数据库
同方法一
实验步骤
1.试验前准备
同方法一
2.分离培养基的配置
首先根据样品数量和试验重复计算所需培养基的用量,然后根据配方称取和配制适量的培养基,调至合适pH,高温灭菌后,待培养基冷却至50 °C左右倒板备用。
注:每种培养基在配置过程中,可根据样品本身的特性和实验需要,设置不同盐梯度,如5%、10%、15%、20%和25%等,以此添加不同质量的NaCl或者KCl,NaCl和MgCl2等复合盐。涂板时每个处理做2个重复。
培养基配方参考如下 (g/L) :
2.1放线菌ISP5培养基(Gottlieb and Shirling,1966):酵母粉5 g,甘油10 g,L-天门冬酰胺1 g, K2HPO4 1 g, KNO3 5 g, MgCl2·6H2O 50 g,微量盐1 mL,琼脂粉12 g,加入蒸馏水定容至1000 mL, pH 7.2–7.4。微量盐配方:FeSO4·7H2O 0.2 g, MnCl2·4H2O 0.1 g, ZnSO4·7H2O 0.1 g,蒸馏水100 mL。
2.2放线菌淀粉酪素培养基(沈硕,2017):淀粉 10 g,水解酪素 0.3 g, KNO3 2 g, MgSO4·7H2O 0.05 g, K2HPO4 2 g, CaCO3 0.02 g, FeSO4·7H2O 10 mg, NaCl 50 g,琼脂粉 12 g,加入蒸馏水定容至1000 mL,pH 7.2–7.4。
2.3放线菌改良淀粉酪素培养基(沈硕,2017):葡萄糖 10 g,水解酪素 0.3 g,KNO3 2 g, MgSO4·7H2O 0.05 g,K2HPO4 2 g,CaCl2·2H2O 1 g,FeSO4·7H2O 10 mg,NaCl 50 g,琼脂粉 12 g,加入蒸馏水至定容1000 mL,pH 7.2–7.4。
2.4CM改良培养基(沈硕,2017):水解酪素 7.5 g,酵母粉 10 g,柠檬酸三钠 3 g,MgSO4·7H2O 20 g,KCl 2 g,FeSO4·7H2O 0.05 g,NaCl 30 g,琼脂粉 12 g,加入蒸馏水定容至1000 mL,pH 7.2–7.4。
2.5CCMS培养基(田蕾等,2017):纤维素10 g,干酪素0.3g,KNO3 0.2 g,MgSO4·7H2O 0.05 g, CaCO3 0.02 g,FeSO4 0.01 g,KCl 20 g,MgCl2 30 g,NaCl 50/100/150 g,琼脂糖15 g,pH 7.5。
2.6甘油精氨酸培养基(夏占峰,2011):甘油5g,精氨酸0.5g,葡萄糖1g,K2HPO4 0.3g,MgSO4·7H2O 5g,维生素母液0.5mg,微量盐溶液1 mg,琼脂20 g,加入蒸馏水定容至1000 mL,121 °C高压灭菌30 min。
2.7放线菌ISP2培养基(Gottlieb and Shirling,1966) :酵母粉4 g,葡萄糖4 g,麦芽膏10 g,微量盐溶液1 mL,琼脂20 g, pH 7.2-7.4。
2.8改良高氏一号培养基:可溶性淀粉 (Soluble starch) 20 g,KNO3 1 g,MgSO4.7H2O 0.5 g,K2HPO4 0.5 g,Agar 12 g,微量盐1 mL。
3.样品预处理
对于嗜盐放线菌的分离,一般需要先将样品提前进行干燥处理。
3.1将采回的样品置于带有无菌滤纸的培养皿中,于超净工作台风干
3.2称取5 g干燥后的样品,倒入装有45 mL无菌超纯水 (含有10%的无菌NaCl,提前装好玻璃珠) 的三角瓶,震荡混匀,然后用三种方法进行预处理:
1)放入80 ºC烘箱中处理20 min
2)置于120W, 2450 MHz微波条件下处理3 min,28 ºC震荡20 min
3)经紫外灯 (100W) 垂直照射10 min
注:以上处理方法依据个人实验目的进行选择,也可不进行高温,微波或紫外处理,直接在摇床震荡培养30 min即可。
4.样品稀释及涂布
4.1将经过预处理的样品进一步稀释成浓度为10-3或10-4的悬浊液;
4.2依次将每个样品,每个浓度下的悬浊液100 μL涂布于分离培养基;
4.3涂布后的平板置于黑暗条件下于37 °C倒置培养1-2周,观察并记录生长情况。
5.菌株分离纯化
待分离培养皿上的单菌落长到合适的丰度时,可开始下一步的纯化。依据菌落形态 (形状、大小、颜色及表面特征) ,挑取单菌落进行纯化。先用记号笔在培养皿的底部标记好待纯化的菌株,并将其按顺序编号。尽量全面挑取不同形态、颜色、大小的菌落以避免重复。挑选完成后,在超净工作台中利用接种针挑取单菌落到纯化板上,采用三区划线法进行纯化。菌株纯化过程中,需要对每株菌做好标记并进行不同编号处理。当菌株在培养基中获得形态一致的单一菌落时即获得微生物纯培养物。
6.菌株16S rRNA基因鉴定
同方法一
7.菌株系统发育学分析
同方法一
8.菌株保藏
同方法一
方法三: 嗜盐古菌分离培养及保藏方法
摘要:嗜盐古菌作为重要的微生物组成部分,参与盐湖生境的生态形成及变化,具有重要的生态功能。嗜盐古菌能利用特殊的胞外及胞内酶(如:淀粉酶、纤维素酶、木聚糖酶、几丁质酶、果胶酶、脂肪酶、酯酶、蛋白酶等)通过水解有机质参与到碳/氮循环中,许多嗜盐古菌具有生物解磷作用。针对不同环境,改进可培养方法在实现不可培养微生物的可培养化、增加稀有及新分类单元的检出率方面,起着重要作用。在实验室条件下分离培养盐湖环境中的嗜盐古菌,深度了解盐湖嗜盐古菌的多样性,充分挖掘盐湖环境有用嗜盐古菌资源,评估其开发应用潜力, 为今后的工业化利用奠定基础。
关键词: 盐湖,分离,纯培养,古菌,保藏
材料与试剂
1. 无机盐:NaCl,KCl,CaCl2,KNO3,CaCO3,FeSO4·7H2O,KH2PO4,K2HPO4,MnCl2·4H2O,MgCl.6H2O,ZnSO4·7H2O,CuSO4·5H2O,NH4Cl,MgSO4·7H2O,丙酮酸钠,柠檬酸三钠等;
2. 碳源或氮源:可溶性淀粉,葡萄糖,甘油,酵母粉,蛋白胨,鱼蛋白胨,干酪素,纤维素,酪蛋白水解氨基酸,藕粉,麦芽膏,微晶纤维素,谷氨酸钠等;
3. 其它溶剂和试剂:琼脂,脱脂奶粉,甘油,干酪素,水解酪素,Chelex,等;
4. 实验用品和耗材:研钵,研磨棒,涂布棒,接种针,90 mm的无菌培养皿, 15 mL无菌离心管,100 mL锥形瓶,各种型号的移液器吸头 (20 μL, 200 μL, 1000 μL),天平,记号笔,酒精灯,安瓿瓶,2 mL冻存管,电磁炉等。
仪器设备
同方法一
软件和数据库
MEGA 7.0(https://www.megasoftware.net/)
EzBioCloud (https://www.ezbiocloud.net/)
CLUSTAL-X1.8(http://www.clustal.org/)
实验步骤
1.样品预处理
采用自然风干法对样品进行预处理,准备内置三层滤纸的无菌培养皿,将样品至于培养皿中,自然风干样品3-5 d。对于水样样品可直接利用水样进行稀释,同时在培养基设计上可利用水样直接代替培养基的蒸馏水 (Burns et al., 2004) 。
2.培养基选择及配置
2.1常规分离培养基
1)高氏培养基 (Liu et al., 2013) :可溶性淀粉20 g, KNO3 1 g, MgSO4·7H2O 0.5 g, K2HPO4 0.5 g, NaCl 150 or 200 g,微量盐 (2% FeSO4·7H2O, 1% MnCl2·4H2O, 1% ZnSO4·7H2O, 1% CuSO4·5H2O) 1 mL,蒸馏水1000 mL, pH 7.2
2)NOM/NHM分离培养基 (Cui et al., 2012) (Han and Cui, 2014):酵母粉 0.05 g,鱼蛋白胨 0.25 g, 丙酮酸钠 1.0 g, KCl 5.4 g, K2HPO4 0.3 g, CaCl2 0.29 g, NH4Cl 0.27 g, MgSO4·7H2O 26.8 g, MgCl2·6H2O 23.0 g, NaCl 184 g,微量盐 1 mL,琼脂18.0 g/L,蒸馏水1000 mL, pH 7.0-7.5
3)CM培养基 (Asker and Ohta, 1999) :酵母粉10 g, 酪蛋白水解物 7.5 g, NaCl 250 g, MgSO4·7H2O 40 g, KCl 2 g,柠檬酸三钠3 g,蒸馏水1000 mL, pH 7.2
4)HM (Halophile medium) 培养基:酵母粉 5 g, MgSO4·7H2O 20 g, K2SO4 5 g, CaCl2·2H2O 0.1 g, NaCl 180 g,琼脂18.0 g,蒸馏水1000 mL, pH 7.2
2.2改良及其它培养基
1)改良高氏培养基 (Liu et al., 2019) :可溶性淀粉5 g,藕粉5 g, KNO3 1 g, MgSO4·7H2O 0.5 g, K2HPO4 0.5 g, NaCl 150 or 200 g,微量盐 (2% FeSO4·7H2O, 1% MnCl2·4H2O, 1% ZnSO4·7H2O, 1% CuSO4·5H2O) 1 mL,蒸馏水1000 mL, pH 7.2
2)改良T3培养基 (Liu et al., 2014) (Tang et al., 2008) :微晶纤维素10 g,干酪素0.3 g, KNO3 2 g, MgCl2·6H2O 30 g, KCl 20 g, K2HPO4·3H2O 0.2 g, CaCO3 0.02 g, MgCl2·6H2O 3 g, NaCl 200 g,微量盐1 mL,琼脂18.0 g/L,蒸馏水1000 mL, pH 7.2
3)改良R2A培养基:酵母粉0.5 g,可溶性淀粉0.5 g,蛋白胨0.5 g,葡萄糖0.5 g,丙酮酸钠0.3 g, K2HPO4 0.3 g, NaCl 200 g, MgSO4 0.024 g,琼脂18 g,蒸馏水1000 mL, pH 7.2
4)C培养基:酵母粉1.0 g,酪蛋白水解物 1.0 g,谷氨酸钠0.5 g,KCl 1.0 g,柠檬酸三钠1.5 g, MgSO4·7H2O 5.0 g, NaCl 180 g,琼脂18.0 g, 蒸馏水1000 mL, pH 7.2
注:培养基盐浓度可以设置盐浓度梯度 (Elshahed et al., 2004) 或者结合样品理化信息设计寡营养培养基进行分离。
3.分离方法
3.1梯度稀释法
取处理后的样品5 g,放入含有50 mL 15 % NaCl的三角瓶内,制作10-1菌悬液,放入摇床内37 °C下活化24 h。采用梯度稀释至终浓度为10-2、10-3或10-4,取100 μL均匀涂布于分离培养基上。对于稀有类群可选择氮源寡营养培养基,如:5 μM 氨基酸 + 5 μM 丙酮酸 (Medium A) ; 5 μM氨基酸+ 5 μM丙酮酸+ 5 μM 醋酸 (Medium B) ; 50 μM氨基酸+ 0.5 % (wt/vol) 丙酮酸(Medium C) ; and 50 μM氨基酸+ 50 μM p丙酮酸+ 50 μM醋酸(Medium D) ,选择10-6-10-10进行稀释分离 (Burns et al., 2004) 。
3.2直接涂布法
将风干样品进行撵磨,选用无菌棉棒蘸取少许样品,采用三线或者四线法接种于分离培养基上。挑选最后一笔的单一菌落进行纯化。
3.3培养条件
通常情况下37 °C黑暗条件下培养3周以上,或者设置不同培养温度进行培养。
4.16S rRNA基因测序
纯化菌株采用细菌基因组DNA提取试剂盒进行基因组提取,选用P1:5'-ATTCCGGTTGATCCTGCCGGA-3',P2:5'-AGGAGGTGATCCAGCCGCAG-3' (王振雄 et al., 2000) 、0018F:5'- ATTCCGGTTGATCCTGCC-3',1518R:5'-AGGAGGTGATCCAGCCGC--3' (Cui et al., 2009) 、D30:5'-ATTCCGGTTGATCCTGC-3',D56:5'-GYTACCTTGTTACGAC-3' (Menasria et al., 2018) 等引物进行嗜盐古菌16S rRNA 基因扩增。送广州擎科生物公司进行基因测序分析。通过EzBioCloud进行16S rRNA基因序列比对,分析纯培养嗜盐古菌分类地位。对于16S rRNA基因序列对比相似度小于98.5 %的菌株,作为潜在新种分类单元;相似度小于96 %的菌株,作为潜在新属分类单元。从NCBI数据库下载相近序列,采用CLUSTAL-X1.8进行序列比对,利用MEGA 7.0构建N-J (Neighbour joining) 系统进化树。
5.菌株保藏
采用含5 % NaCl的20 %牛奶,或含有15 % NaCl的30 %甘油对菌株进行保藏;牛奶管于4 °C、甘油管于-80 °C保存。完善菌株信息 (采样地点地理信息、样品理化信息、菌株分离条件信息、菌株形态照片采集及菌株16S rRNA比对信息等) ,科学构建嗜盐古菌资源库。
参考文献
1. Asker, D. and Ohta, Y. (1999). Production of canthaxanthin by extremely halophilic bacteria. Journal of Bioscience and Bioengineering 88(6): 617-621. https://doi.org/Doi 10.1016/S1389-1723(00)87089-9
2. Burns, D. G., Camakaris, H. M., Janssen, P. H. and Dyall-Smith, M. L. (2004). Cultivation of Walsby's square haloarchaeon. Fems Microbiology Letters 238(2): 469-473. https://doi.org/10.1016/j.femsle.2004.08.016
3. Cui, H. L., Yang, X., Zhou, Y. G., Liu, H. C., Zhou, P. J. and Dyall-Smith, M. L. (2012). Halobellus limi sp nov and Halobellus salinus sp nov., isolated from two marine solar salterns. International Journal of Systematic and Evolutionary Microbiology 62: 1307-1313. https://doi.org/10.1099/ijs.0.032169-0
4. Cui, H. L., Zhou, P. J., Oren, A. and Liu, S. J. (2009). Intraspecific polymorphism of 16S rRNA genes in two halophilic archaeal genera, Haloarcula and Halomicrobium. Extremophiles 13(1): 31-37. https://doi.org/10.1007/s00792-008-0194-2
5. Elshahed, M. S., Najar, F. Z., Roe, B. A., Oren, A., Dewers, T. A. and Krumholz, L. R. (2004). Survey of archaeal diversity reveals an abundance of halophilic Archaea in a low-salt, sulfide- and sulfur-rich spring. Applied and Environmental Microbiology 70(4): 2230-2239. https://doi.org/10.1128/Aem.70.4.2230-2239.2004
6. Han, D. and Cui, H. L. (2014). Halobacterium rubrum sp. nov., isolated from a marine solar saltern. Archives of Microbiology 196(12): 847-851. https://doi.org/10.1007/s00203-014-1023-x
7. Gottlieb, D., Shirling, E. B. (1966) Methods for characterization of Streptomyces species. International Journal of Systematic Bacteriology 16(3):313-340.
https://doi.org/10.1099/00207713-16-3-313
8. Liu, B. B., Rao, M. P. N., Yin, X. Q., Li, X., Salam, N., Zhang, Y., Alkhalifah, D. H. M., Hozzein, W. N. and Li, W. J. (2019). Description of Halegenticoccus soli gen. nov., sp. nov., a halophilic archaeon isolated from a soil sample of Ebi lake. Extremophiles 23(5): 521-528. https://doi.org/10.1007/s00792-019-01104-9
9. Liu, B. B., Tang, S. K., Cui, H. L., Zhang, Y. G., Li, L., Zhang, Y. M., Zhang, L. L. and Li, W. J. (2013). Halopelagius fulvigenes sp nov., a halophilic archaeon isolated from a lake. International Journal of Systematic and Evolutionary Microbiology 63: 2192-2196. https://doi.org/10.1099/ijs.0.045773-0
10. Liu, B. B., Zhao, W. Y., Chu, X., Hozzein, W. N., Prabhu, D. M., Wadaan, M. A. M., Tang, S. K., Zhang, L. L. and Li, W. J. (2014). Haladaptatus pallidirubidus sp nov., a halophilic archaeon isolated from saline soil samples in Yunnan and Xinjiang, China. Antonie Van Leeuwenhoek International Journal of General and Molecular Microbiology 106(5): 901-910. https://doi.org/10.1007/s10482-014-0259-4
11. Menasria, T., Aguilera, M., Hocine, H., Benammar, L., Ayachi, A., Bachir, A. S., Dekak, A. and Monteoliva-Sanchez, M. (2018). Diversity and bioprospecting of extremely halophilic archaea isolated from Algerian arid and semi-arid wetland ecosystems for halophilic-active hydrolytic enzymes. Microbiological Research 207: 289-298. https://doi.org/10.1016/j.micres.2017.12.011
12. Tang, S. K., Tian, X. P., Zhi, X. Y., Cai, M., Wu, J. Y., Yang, L. L., Xu, L. H. and Li, W. J. (2008). Haloactinospora alba gen. nov., sp. nov., a halophilic filamentous actinomycete of the family Nocardiopsaceae. Int J Syst Evol Microbiol 58(Pt 9): 2075-2080. https://doi.org/10.1099/ijs.0.65531-0
13. 顾晓颖, 李冠 and 生物技术, 吴. J. (2007). 巴里坤湖和玛纳斯湖嗜盐菌的分离及功能酶的筛选. 017(003): 26-30
14. 沈硕 (2017). 青藏高原察尔汗盐湖地区可培养中度嗜盐菌的群落结构与多样性. 微生物学报 57(004): 490-499
15. 田蕾, 李恩源, 关统伟, 唐蜀昆, 刘晓飞 and 张小平 (2017). 艾丁湖可培养嗜盐菌多样性及功能酶_抗菌活性筛选. 微生物学通报 11: 2575-2587. https://doi.org/10.13344/j.microbiol.china.170046
16. 王振雄, 徐毅 and 周培瑾 (2000). 嗜盐碱古生菌新种的系统分类学研究. 40(2): 115-120. https://doi.org/10.13343/j.cnki
17. 夏占峰, 关统伟, 阮继生, 黄英 and 微生物学报, 张. J. (2011). 艾丁湖沉积物放线菌多样性. 51(8)
18. 赵婉雨 (2013). 柴达木盆地达布逊盐湖微生物多样性研究, 中国地质大学(北京).
猜你喜欢
10000+:菌群分析 宝宝与猫狗 梅毒狂想曲 提DNA发Nature Cell专刊 肠道指挥大脑
文献阅读 热心肠 SemanticScholar Geenmedical
16S功能预测 PICRUSt FAPROTAX Bugbase Tax4Fun
生物科普: 肠道细菌 人体上的生命 生命大跃进 细胞暗战 人体奥秘
写在后面
为鼓励读者交流、快速解决科研困难,我们建立了“宏基因组”专业讨论群,目前己有国内外5000+ 一线科研人员加入。参与讨论,获得专业解答,欢迎分享此文至朋友圈,并扫码加主编好友带你入群,务必备注“姓名-单位-研究方向-职称/年级”。PI请明示身份,另有海内外微生物相关PI群供大佬合作交流。技术问题寻求帮助,首先阅读《如何优雅的提问》学习解决问题思路,仍未解决群内讨论,问题不私聊,帮助同行。

学习16S扩增子、宏基因组科研思路和分析实战,关注“宏基因组”
 点击阅读原文下载PDF审稿,或浏览器直接访问下载链接:http://210.75.224.110/github/MicrobiomeProtocol/04Review/210122/2003811WenjunLi959326/Protocol2003811.pdf
点击阅读原文下载PDF审稿,或浏览器直接访问下载链接:http://210.75.224.110/github/MicrobiomeProtocol/04Review/210122/2003811WenjunLi959326/Protocol2003811.pdf























 1086
1086

 被折叠的 条评论
为什么被折叠?
被折叠的 条评论
为什么被折叠?








